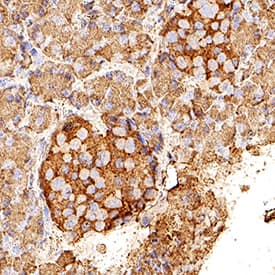

Human VEGF-D Antibody
R&D Systems, part of Bio-Techne | Catalog # MAB286

Key Product Details
Species Reactivity
Validated:
Cited:
Applications
Validated:
Cited:
Label
Antibody Source
Product Specifications
Immunogen
Phe93-Ser201
Accession # O43915
Specificity
Clonality
Host
Isotype
Endotoxin Level
Scientific Data Images for Human VEGF-D Antibody
Detection of VEGF-D in Human Pancreas.
VEGF-D was detected in immersion fixed paraffin-embedded sections of Human Pancreas using Mouse Anti-Human VEGF-D Monoclonal Antibody (Catalog # MAB286) at 1 µg/mL for 1 hour at room temperature followed by incubation with the Anti-Mouse IgG VisUCyte™ HRP Polymer Antibody (VC001). Before incubation with the primary antibody, tissue was subjected to heat-induced epitope retrieval using VisUCyte Antigen Retrieval Reagent-Basic (VCTS021). Tissue was stained using DAB (brown) and counterstained with hematoxylin (blue). Specific staining was localized to pancreatic islets. View our protocol for IHC Staining with VisUCyte HRP Polymer Detection Reagents.Applications for Human VEGF-D Antibody
Immunohistochemistry
Sample: Immersion fixed paraffin-embedded sections of Human Pancreas
Reviewed Applications
Read 1 review rated 5 using MAB286 in the following applications:
Formulation, Preparation, and Storage
Purification
Reconstitution
Formulation
*Small pack size (-SP) is supplied either lyophilized or as a 0.2 µm filtered solution in PBS.
Shipping
Stability & Storage
- 12 months from date of receipt, -20 to -70 °C as supplied.
- 1 month, 2 to 8 °C under sterile conditions after reconstitution.
- 6 months, -20 to -70 °C under sterile conditions after reconstitution.
Background: VEGF-D
Vascular endothelial growth factor D (VEGF-D), also known as c-fos-induced growth factor (FIGF), is a secreted glycoprotein of the VEGF/PDGF family. VEGFs regulate angiogenesis and lymphangiogenesis during development and tumor growth, and are characterized by eight conserved cysteine residues that form a cystine knot structure (1-3). VEGF-C and VEGF-D, which share 23% amino acid (aa) sequence identity, are uniquely expressed as preproproteins that contain long N- and C‑terminal propeptide extensions around the VEGF homology domain (VHD) (1, 2). Proteolytic processing of the 354 aa VEGF-D preproprotein creates a secreted proprotein. Further processing by extracellular serine proteases, such as plasmin or furin-like proprotein convertases, forms mature VEGF-D consisting of non‑covalently linked 42 kDa homodimers of the 117 aa VHD (4-6). Mature human VEGF-D shares 94%, 95%, 99%, 97%, and 93% aa identity with mouse, rat, equine, canine, and bovine VEGF-D, respectively (4, 5). It is expressed in adult lung, heart, muscle, and small intestine, and is most abundantly expressed in fetal lungs and skin (1-4). Mouse and human VEGF-D are ligands for VEGF Receptor 3 (VEGF R3, also called Flt-4) that are active across species and show enhanced affinity when processed (7). Processed human VEGF-D is also a ligand for VEGF R2, also called Flk-1 or KDR (7). VEGF R3 is strongly expressed in lymphatic endothelial cells and is essential for regulation of the growth and differentiation of lymphatic endothelium (1, 2). While VEGF-C is the critical ligand for VEGF R3 during embryonic lymphatic development, VEGF-D is most active in neonatal lymphatic maturation and bone growth (8-10). Both promote tumor lymphangiogenesis (11). Consonant with their activity on VEGF receptors, binding of VEGF-C and VEGF-D to neuropilins contributes to VEGF R3 signaling in lymphangiogenesis, while binding to integrin alpha9 beta1 mediates endothelial cell adhesion and migration (12, 13).
References
- Roy, H. et al. (2006) FEBS Lett. 580:2879.
- Otrock, Z.H. et al. (2007) Blood Cells Mol. Dis. 38:258.
- Yamada, Y. et al. (1997) Genomics 42:483.
- Stacker, S.A. et al. (1999) J. Biol. Chem. 274:32127.
- McColl, B.K. et al. (2003) J. Exp. Med. 198:863.
- McColl, B.K. et al. (2007) FASEB J. 21:1088.
- Baldwin, M.E. et al. (2001) J. Biol. Chem. 276:19166.
- Baldwin, M.E. et al. (2005) Mol. Cell. Biol. 25:2441.
- Karpanen, T. et al. (2006) Am. J. Pathol. 169:708.
- Orlandini, M. et al. (2006) J. Biol. Chem. 281:17961.
- Stacker, S.A. et al. (2001) Nature Med. 7:186.
- Karpanen, T. et al. (2006) FASEB J. 20:1462.
- Vlahakis, N.E. et al. (2005) J. Biol. Chem. 280:4544.
Long Name
Alternate Names
Gene Symbol
UniProt
Additional VEGF-D Products
Product Documents for Human VEGF-D Antibody
Product Specific Notices for Human VEGF-D Antibody
For research use only